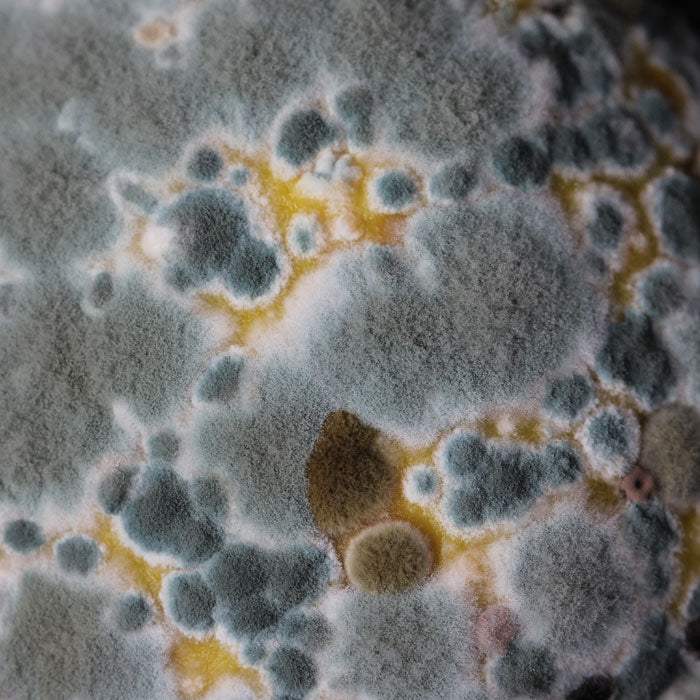

Mold is Difficult to Remove
Moldy shoes often have a pungent, sour smell that is difficult to remove. Aspergillus mold is the most typical fungi that can grow on leather shoes and can be harmful to human and pet health. Cleaning the surface area with soap and water alone will not eliminate the mold. An anti-mold fungicide must be used to completely remove mold.
- Before using a fungicide, put on gloves and a mask and take the shoes outdoors.
- Use a stiff nylon brush to rub the surface of the leather with the fungicide.
- Use a soft cloth with a mixture of vinegar and water to wipe down the full surface of the shoe to kill 75% of the mold.
- If mold persists after a few days, wipe the surface with isopropyl alcohol after checking its effect on a hidden part of the shoe to make sure it does not change the color or appearance.

- Use a leather conditioner after the alcohol to keep the shoe completely dry.
- Don’t forget about the soles: Hydrolysis damage (when polymers are broken down into monomers) occurs when moisture builds up in the soles of footwear. If not worn regularly or stored correctly, moisture can build up and cause the soles to break down and separate through hydrolysis
More Shoe Storage and Care Tips
Preventing Mold & Bacteria on Shoes
Check new shoes for any signs of mold or moisture…
Before using a fungicide, put on gloves…
How to Remove Creasing in Leather Shoes
Using warm water, dampen a white washcloth…
How to Clean Leather Shoes and Boots
Brush off dirt and debris with soft bristled brush…
How to Clean Suede and Nubuck Shoes
For most suede/nubuck cleanings, do not use water…
How to Clean Canvas and Mesh Shoes
Cover your workspace with a large rag or towel…
Brush dirt and debris off the sole with a dry brush…
How to Clean Shoe & Boot Laces
For cotton, cloth laces prepare a bowl of hot water…


